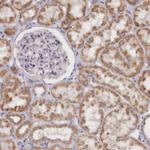
DCUN1D1 Antibody in Immunohistochemistry (Paraffin) (IHC (P))

Search
Invitrogen
DCUN1D1 Polyclonal Antibody
{{$productOrderCtrl.translations['antibody.pdp.commerceCard.promotion.promotions']}}
{{$productOrderCtrl.translations['antibody.pdp.commerceCard.promotion.viewpromo']}}
{{$productOrderCtrl.translations['antibody.pdp.commerceCard.promotion.promocode']}}: {{promo.promoCode}} {{promo.promoTitle}} {{promo.promoDescription}}. {{$productOrderCtrl.translations['antibody.pdp.commerceCard.promotion.learnmore']}}
产品信息
PA5-83298
种属反应
宿主/亚型
分类
类型
抗原
偶联物
形式
浓度
规格
纯化类型
保存液
内含物
保存条件
运输条件
RRID
产品详细信息
Immunogen sequence: RQFMIFTQSS EKTAVSCLSQ NDWKLDVATD NFFQNPELYI RESVKGSLDR KKLEQLYNR
Highest antigen sequence indentity to the following orthologs: Rat - 100%, Mouse - 98%.
靶标信息
Part of an E3 ubiquitin ligase complex for neddylation. Promotes neddylation of cullin components of E3 cullin-RING ubiquitin ligase complexes. Acts by binding to cullin-RBX1 complexes in the cytoplasm and promoting their nuclear translocation, enhancing recruitment of E2-NEDD8 (UBE2M-NEDD8) thioester to the complex, and optimizing the orientation of proteins in the complex to allow efficient transfer of NEDD8 from the E2 to the cullin substrates. Involved in the release of inhibitory effets of CAND1 on cullin-RING ligase E3 complex assembly and activity (PubMed:25349211, PubMed:28581483). Acts also as an oncogene facilitating malignant transformation and carcinogenic progression. [UniProt]
仅用于科研。不用于诊断过程。未经明确授权不得转售。
篇参考文献 (0)
生物信息学
蛋白别名: DCN1, defective in cullin neddylation 1, domain containing 1; DCN1-like protein 1; DCNL1; DCUN1 domain-containing protein 1; Defective in cullin neddylation protein 1-like protein 1; leucine zipper protein; RP42 homolog; Squamous cell carcinoma-related oncogene; unnamed protein product
基因别名: DCN1; DCNL1; DCUN1D1; DCUN1L1; RP42; SCCRO; SCRO; Tes3
UniProt ID: (Human) Q96GG9
Entrez Gene ID: (Human) 54165